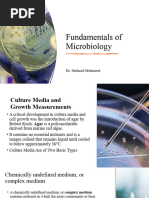

0% found this document useful (0 votes)
14 views11 pagesSlide 20 HA
The document outlines viable count procedures for microorganisms, focusing on two major techniques: Plate Count and Most Probable Number (MPN). It details the key features, limitations, and methodologies involved in these techniques, including sample preparation, colony counting, and the use of selective and differential media. Additionally, it discusses the importance of colony hybridization for detecting specific DNA sequences in microbial studies.
Uploaded by
nirobrahman9988Copyright
© © All Rights Reserved
We take content rights seriously. If you suspect this is your content, claim it here.
Available Formats
Download as PDF, TXT or read online on Scribd
0% found this document useful (0 votes)
14 views11 pagesSlide 20 HA
The document outlines viable count procedures for microorganisms, focusing on two major techniques: Plate Count and Most Probable Number (MPN). It details the key features, limitations, and methodologies involved in these techniques, including sample preparation, colony counting, and the use of selective and differential media. Additionally, it discusses the importance of colony hybridization for detecting specific DNA sequences in microbial studies.
Uploaded by
nirobrahman9988Copyright
© © All Rights Reserved
We take content rights seriously. If you suspect this is your content, claim it here.
Available Formats
Download as PDF, TXT or read online on Scribd